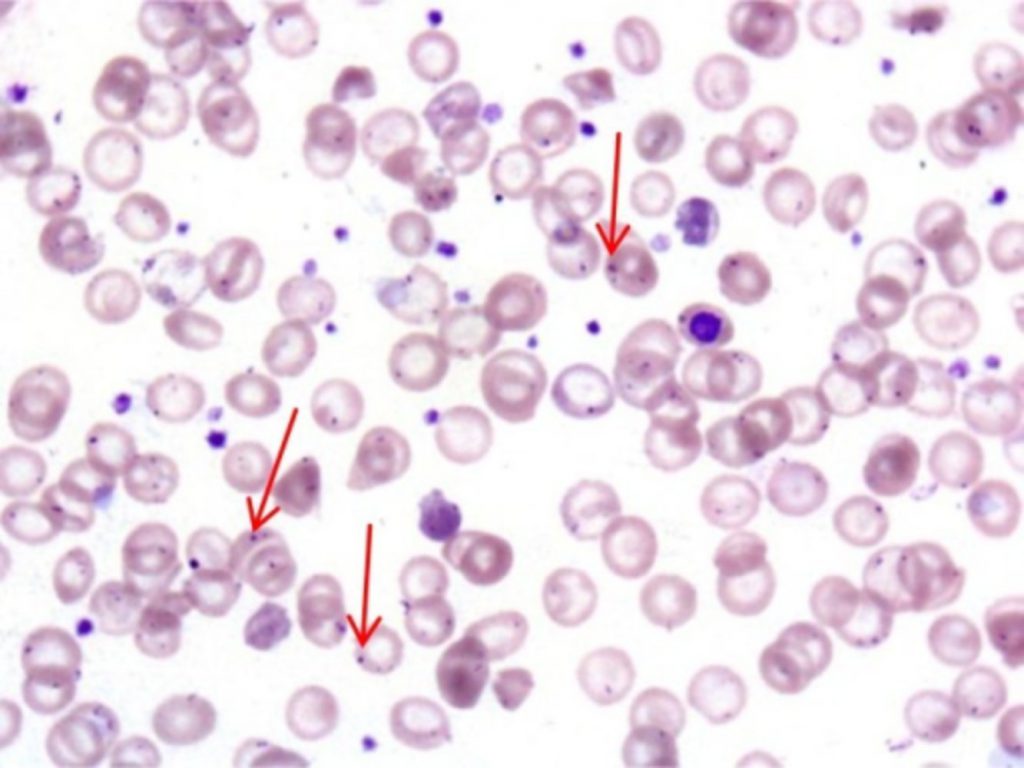

بیماری دیورتیکولار

بیماری دیورتیکولار شامل یک سری از مشکلات کولونd است که باعث بیرون زدگی غیر نرمال لایه مخاطی کولون به بیرون میشوند (دیورتیکول). این بیماری به دو دستهی دیورتیکولوز (دیورتیکول غیر التهابی) و دیورتیکولیت (دیورتیکول التهابی) تقسیم میشود. رخداد دیورتیکول کولون میتواند به خاطر افزایش فشار داخل مجرای کولون به صورت مزمن به خاطر یبوست (مثلاً به دلیل فیبر کم در داخل غذا، نبود فعالیت بدنی) و ضعیف شدن بافت همبند در ارتباط با افزایش سن باشد. همین عوامل باعث میشود که لایه مخاطی از طریق ناحیه ضعیف شده به داخل لایه عضلانی فتق پیدا کند.
بیماران بدون طحال
طحال جزء سیستم رتیکولواندتلیال میباشد که مسئول حذف اریتروسیتهای آسیب دیده و اپسونیزاسیون ارگانیسمهای کپسول دار از جریان خون میباشد. آسپلنیا (نداشتن طحال) به دو صورت آناتومیک (جراحی الکتیو یا اورژانسی) و عملکردی (بیماری زمینهای) ایجاد میشود. در اسمیر خون محیطی بیماران بدون طحال، اجسام هووِل-ژولی دیده میشود، همچنین نوتروفیلی و ترومبوسیتوز نیز از تظاهرات آن میباشد.
بلع باریم

باریم سوالوی مری، که به عنوان ازوفاگوگرام نیز شناخته میشود، نوعی مطالعهی رادیوگرافی با کنتراست زیاد جهت بررسی مری میباشد. این روش به ما اجازه مطالعه عملکرد و آناتومی مری را میدهد. همچنین در ارزیابی دیسفاژی، اودینوفاژی و رگورژیتاسیون (برگشت غذا به داخل دهان) میتواند استفاده شود. مانومتری مری روش تشخیصی انتخابی برای اختلالات حرکتی مری میباشد.
ایسکمی روده

کاهش خونرسانی روده میتواند بصورت حاد یا مزمن روده کوچک یا بزرگ را تحت تاثیر قرار دهد. ترومبوآمبولی، آترواسکلروز و هایپوتنشن شدید میتوانند از دلایل رخداد این شرایط باشد. این بیماری ممکناست به صورت درد شکمی بعد از غذا و اسهال خونی تظاهر مییابد. در موارد شدید انفارکتوس، پارگی روده سبب سپسیس و مرگ میشود.
انسداد روده

انسداد روده به قطع جریان طبیعی محتوای روده گفته میشود که میتواند به دلیل انسداد عملکردی یا مکانیکی باشد. انسداد عملکردی روده یا ایلئوس پارالیتیک، یک اختلال موقتی در حرکات دودی روده در غیاب انسداد مکانیکی است (نگاه کنید به “ایلئوس فلجکننده”). انسداد مکانیکی روده به منزله قطع شدن جریان طبیعی روده به دلیل وجود مانع ساختاری است. انسداد مکانیکی روده را میتوان با توجه به محل آن به دو گروه انسداد روده باریک (SBO) یا انسداد روده بزرگ (LBO) طبقه بندی کرد یا براساس میزان انسداد،به پارشیل یا کامل طبقه بندی کرد.
اسپلنومگالی

اسپلنومگالی به بزرگی طحال گفته میشود. علت میتواند افزایش فعالیت طحال، کاهش درناژ طحال یا انفیلتراسیون سلولهای مغزاستخوان در طحال باشد؛ علائم نیز ممکناست در نتیجهی افزایش سایز و اثرات فشاری برروی بافتهای اطراف ظاهر شود، یا سبب کاهش هر یک از سلولهای خونی گردد و آنمی، لکوپنی، ترومبوسیتوپنی یا پانسیتوپنی (کاهش همه ردهها) ایجاد نماید.
آلرژیهای غذایی
آلرژیهای غذایی واکنشهای ازدیاد حساسیت به مواد موجود در غذا هستند. آنها شایعترین علت بستری اورژانسی مرتبط با آنافیلاکسی هستند. کودکان خردسال معمولاً تحت تأثیر این اختلال قرار میگیرند. این بیماری معمولاً از دو سال اول زندگی آغاز میشود. واکنشهای مرتبط با IgE، شایعترین نوع هستند و طی چند دقیقه پس از مصرف شکل میگیرند.
آشالازی

آشالازی اختلال در شل شدن اسفنکترتحتانی مری است که به علت تخریب و دژنراسیون نورونهای مهاری دیوارهی مری ایجاد میشود. این بیماری دردو فرم اولیه یا ایدیوپاتیک و ثانویه در زمینهی بیماریهای دیگر ایجاد میشود. در بیماران آشالازی، شکایت اصلی دیسفاژی به جامدات و مایعات، برگشت غذا به دهان، درد پشت جناغ و کاهش وزن میباشد. از اندوسکوپی فوقانی، بلع باریم و مانومتری مری میتوان جهت تشخیص استفاده کرد.
آبسه کبدی پیوژنیک

آبسه کبدی پیوژنیک یک بیماری نادر است که با تجمعهای منفرد/ چندگانه مملوء از چرک در کبد مشخص میشود. این عفونت توسط باکتری ها ایجاد میشود و معمولاً چند میکروبی است و اکلای و کلبسیلا پنومونی ارگانیسمهای اصلی ایجادکننده هستند. در بیشتر موارد صعود عامل عفونی در اثر وجود مجاری صفراوی غیرطبیعی اتفاق میافتد (کلانژیت ناشی از سنگ مجرای صفراوی مشترک، تنگی مجاری).
سندرم روده تحریکپذیر (IBS)
سندرم روده تحریک پذیر (IBS) یک بیماری مزمن شایع است که حدود ۲۰-۵۰% از شکایات دستگاه گوارش را تحت تأثیر قرار میدهد. پاتوفیزیولوژی ِدقیق، ناشناخته است، اما ممکن است تغییراتی در تحرک دستگاه گوارش، حساسیت زیاد احشایی و تغییر نفوذپذیری دستگاه گوارش داشته باشد.
